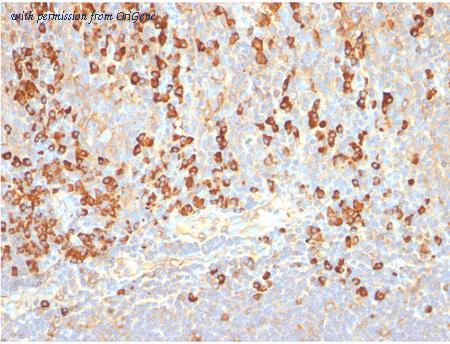

product summary
Loading...
company name :
OriGene
product type :
antibody
product name :
Plasma Cell Mouse Monoclonal Antibody [Clone ID: LIV3G11]
catalog :
AM32826PU-T
quantity :
20 µg
price :
293 USD
clonality :
monoclonal
host :
mouse
conjugate :
nonconjugated
clone name :
LIV3G11
application :
immunohistochemistry
more info or order :
image
image 1 :
Formalin-paraffin human tonsil stained with Plasma Cell Marker MAb (Clone LIV3G11).
product information
SKU :
AM32826PU-T
Category :
Antibodies
Sub-Category :
Primary Antibodies
Name :
Plasma Cell Mouse Monoclonal Antibody [Clone ID: LIV3G11]
Description :
Plasma Cell mouse monoclonal antibody, clone LIV3G11, Purified
Size :
20 µg
Price US :
293 USD
Delivery Time US :
2 Weeks
Clonality :
Monoclonal
Clone Name :
LIV3G11
Host :
Mouse
Isotype :
IgG2a
Applications :
IHC
Reactivity :
Human
more info or order :
company information

OriGene
9620 Medical Center Dr., Suite 200
Rockville, MD 20850
Rockville, MD 20850
custsupport@origene.com
https://www.origene.com1-888-267-4436
headquarters: USA
OriGene Technologies, Inc. is a gene centric life sciences company dedicated to support biomedical scientists in gene functions and drug discovery. OriGene’s novel product line includes the world’s largest collections of cDNA clones (TrueClone and TrueORF), shRNA (HuSH-29), purified human recombinant proteins, high quality TrueMAB™ monoclonal antibodies to human proteins, 100,000 highly validated human tissues, and qPCR arrays. OriGene also provides a broad range of antibody validation products including genome-wide tagged antigen standards and extensive IHC slides derived from our tissue collection. OriGene is a Luminex Certified Partner™ and offers multiplexed immunoassays and multiplexed assays for a broad range of biomarkers.
browse more products
- Human Lambda Light Chain Mouse Monoclonal Antibody [Clone ID: HP6054] | AM32827PU-S
- Human Lambda Light Chain Mouse Monoclonal Antibody [Clone ID: HP6054] | AM32827PU-T
- ACTH (POMC) (1-24) Mouse Monoclonal Antibody [Clone ID: AH26] | AM32828PU-S
- ACTH (POMC) (1-24) Mouse Monoclonal Antibody [Clone ID: AH26] | AM32828PU-T
- GFAP Mouse Monoclonal Antibody [Clone ID: GA5] | AM32829PU-S
questions and comments
